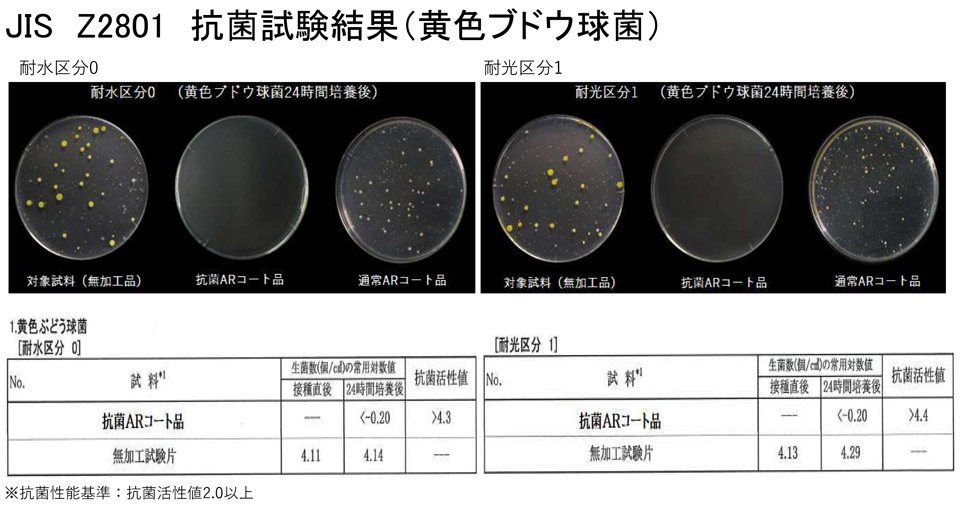
JIS Z2801 抗菌試験結果(黄色ブドウ球菌)
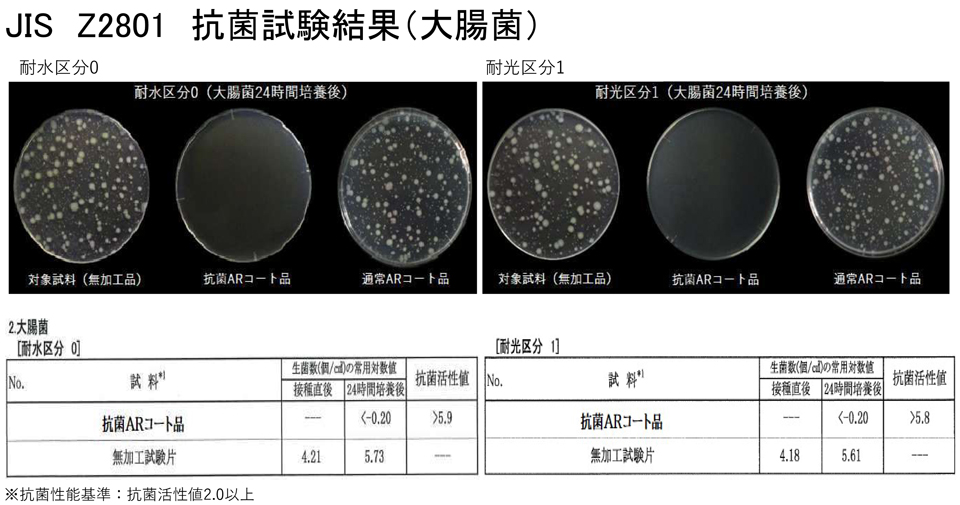
JIS Z2801 抗菌試験結果(大腸菌)

D263 T eco 両面抗菌ARコート付(可視用)
D263 T ecoの両面に抗菌ARコートを施しました。
渋谷光学では光学ウィンドウを各種お取り扱いしております。
ご希望に応じて必要なサイズに加工いたしますのでお問い合わせ下さい。
- 素材:D263®T eco ※SCHOTT社の登録商標です。
- 屈折率(ne):1.525
- 密度(g/cm3):2.51
- 線膨張係数(×10-6/K):7.2
- 技術データはこちらから。(SCHOTT社のホームページへリンクします。)
- 入射角:0°
- 適応波長:400~700nm
- 平均反射率 1.5%以下
- 有効エリア:90%
参考資料
参考図面(WDAR014-76S)
参考特性(WDAR014-76S)
注)記載しているデータは当社の実測値であり、実際の使用条件により得られるデータは異なる場合がありますのでご注意下さい。
価格表
| 型番 |
寸法 |
厚み |
定価 |
| WDAR014-76S |
76×76mm |
0.145mm |
11,000円(税込12,100円) |
| WDAR017-76S |
76×76mm |
0.175mm |
11,000円(税込12,100円) |
| WDAR021-76S |
76×76mm |
0.21mm |
11,000円(税込12,100円) |
| WDAR030-76S |
76×76mm |
0.3mm |
11,000円(税込12,100円) |
| WDAR040-76S |
76×76mm |
0.4mm |
11,000円(税込12,100円) |